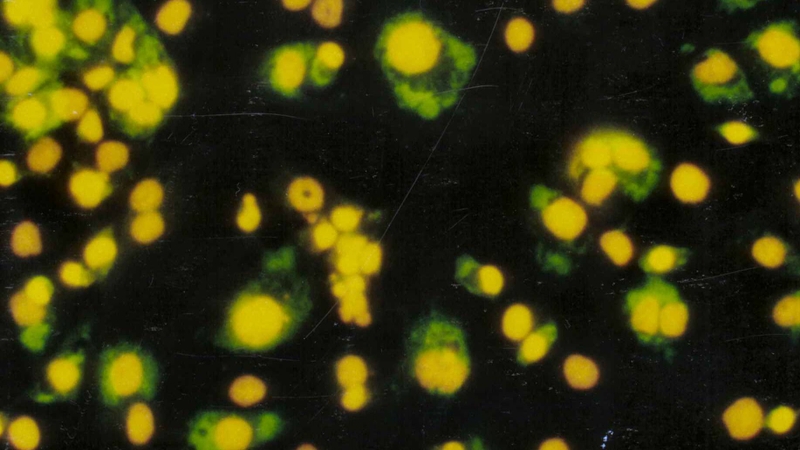
Các tế bào bị nhiễm virus sẽ mang kháng nguyên nội sinh trên bề mặt

Dược sĩ Đại học có nhiều năm kinh nghiệm trong việc tư vấn Dược phẩm và hỗ trợ giải đáp thắc mắc về Bệnh học. Hiện đang là giảng viên cho Dược sĩ tại Nhà thuốc Long Châu.
Quỳnh Loan
19/12/2025
Mặc định
Lớn hơn
Tế bào lympho T là nhóm tế bào miễn dịch quan trọng, giữ vai trò nhận diện, tiêu diệt tác nhân gây bệnh và duy trì sự cân bằng miễn dịch. Hiểu rõ về tế bào lympho T giúp chúng ta giải thích cách cơ thể bảo vệ chính mình hiệu quả.
Hệ miễn dịch của cơ thể phụ thuộc vào nhiều loại bạch cầu khác nhau để nhận biết và ngăn chặn tác nhân gây bệnh. Trong đó, có một nhóm đặc biệt - lympho bào - gồm hai nhóm chính: Lympho B và lympho T. Nhờ vào quá trình biệt hóa và trưởng thành phức tạp, lympho T đảm đương nhiều vai trò quan trọng giúp bảo vệ sức khỏe, như nhận diện và tiêu diệt tế bào bất thường, đồng thời điều hòa phản ứng miễn dịch cho cơ thể.
Tế bào lympho T thuộc nhóm tế bào lympho có nguồn gốc từ tủy xương và trải qua quá trình trưởng thành trong tuyến ức. Tên gọi của chúng bắt nguồn từ chính cơ quan này vì sự biệt hóa chỉ hoàn tất khi các tiền thân tế bào trở thành tế bào T trưởng thành.
Đặc điểm giúp phân biệt tế bào lympho T với các loại lympho khác là sự hiện diện của thụ thể tế bào T nằm trên bề mặt. Thụ thể này đóng vai trò quan trọng, cho phép tế bào nhận diện kháng nguyên và khởi phát các phản ứng miễn dịch đặc hiệu. Trong nhóm tế bào lympho T có hai phân nhóm chính gồm: Tế bào T hỗ trợ và tế bào T gây độc, mỗi loại đóng một vai trò khác nhau trong bảo vệ cơ thể.
Các nhà miễn dịch học phân loại tế bào lympho T dựa trên chức năng và đặc tính bề mặt của chúng:
Cả hai nhóm này hoạt động phối hợp tạo nên hệ thống phòng thủ tinh vi giúp duy trì sự ổn định của môi trường nội môi.

Trong hệ miễn dịch đặc hiệu, tế bào lympho T chỉ được kích hoạt khi nhận diện đúng tín hiệu. Các phản ứng miễn dịch của tế bào T diễn ra theo quy trình chặt chẽ để tránh tình trạng tấn công nhầm vào tế bào khỏe mạnh. Để khởi động phản ứng này, cơ thể cần có sự tham gia của các tế bào trình diện kháng nguyên.
Quá trình hoạt hóa của tế bào lympho T được điều khiển bởi hai tín hiệu quan trọng. Đầu tiên, tế bào trình diện kháng nguyên như đại thực bào hoặc tế bào đuôi gai bắt giữ tác nhân gây bệnh, phân giải chúng thành các đoạn peptide rồi gắn lên phân tử MHC lớp II trước khi trình diện trên bề mặt. Trong lúc này, tế bào trình diện kháng nguyên cũng biểu hiện phân tử B7. Khi tế bào lympho T gặp kháng nguyên phù hợp, thụ thể bề mặt của chúng sẽ gắn với phức hợp MHC mang đoạn peptide lạ.
Tiếp theo, phối tử CD28 trên tế bào lympho T sẽ gắn với phân tử B7 của tế bào trình diện kháng nguyên để gửi tín hiệu thứ hai hoàn tất quá trình hoạt hóa.
Sau khi được kích hoạt, tế bào lympho T đảm nhiệm nhiều nhiệm vụ quan trọng trong đáp ứng miễn dịch. Chúng tham gia điều phối và hỗ trợ hoạt động của nhiều loại tế bào khác giúp phản ứng miễn dịch được thực hiện nhanh chóng và chính xác.
Tế bào lympho T có khả năng nhận diện kháng nguyên một cách đặc hiệu. Kháng nguyên được chia thành hai nhóm gồm nội sinh và ngoại sinh, tùy vào nguồn gốc xuất phát. Các tế bào bị nhiễm virus sẽ mang kháng nguyên nội sinh trên bề mặt, còn đại thực bào tiết ra kháng nguyên ngoại sinh khi tiêu hóa tác nhân gây bệnh. Cả hai loại tín hiệu này đều giúp tế bào lympho T nhận biết mục tiêu cần xử lý.
Tế bào lympho T không chỉ tấn công tác nhân gây bệnh mà còn giúp điều hòa phản ứng miễn dịch. Nhóm tế bào T điều hòa hay còn gọi là Ts đóng vai trò kiểm soát giúp ngăn chặn tình trạng phản ứng quá mức. Chúng tiết interleukin để hạn chế hoạt động của kháng nguyên khi lượng kháng nguyên dư thừa. Cơ chế này bảo vệ tế bào lành tránh bị tổn thương và giảm nguy cơ mắc bệnh tự miễn.
Tế bào T gây độc đóng vai trò loại bỏ trực tiếp tế bào bất thường thông qua cơ chế giải phóng enzyme gây độc. Khi kháng nguyên đã đánh dấu tế bào gây hại, tế bào T gây độc sẽ tấn công bằng perforin và granzymes dẫn đến chết tế bào theo chương trình. Một số tác nhân gây bệnh có thể tránh được cơ chế này nên tế bào T gây độc còn huy động phản ứng quá mẫn muộn để tăng cường chiêu mộ đại thực bào.
Sự bất thường trong số lượng hoặc chức năng tế bào lympho T có thể dẫn đến nhiều bệnh lý nghiêm trọng. Các rối loạn này được phân thành tình trạng giảm hoặc tăng tế bào tùy vào nguyên nhân.
Khi cơ thể không sản xuất đủ tế bào T, khả năng bảo vệ trước tác nhân gây bệnh bị suy yếu nghiêm trọng. Tình trạng này thường gặp ở những người mắc rối loạn bẩm sinh hoặc nhiễm virus làm suy giảm miễn dịch như HIV. Một số liệu pháp điều trị hoặc thuốc đặc hiệu cũng có thể làm giảm tế bào T. Nếu số lượng giảm mạnh, cơ thể mất khả năng chống nhiễm trùng và nguy cơ đe dọa tính mạng tăng cao.

Số lượng tế bào lympho T tăng ít phổ biến hơn nhưng có thể xuất hiện khi cơ thể đang chống nhiễm trùng hoặc khi mắc một số bệnh ung thư hệ bạch huyết. Việc tăng sinh bất thường cần được đánh giá để xác định nguyên nhân nhằm tránh diễn tiến thành bệnh ác tính.
Nhiều bệnh lý có thể tác động tiêu cực đến hoạt động của tế bào lympho T vì chúng có liên quan trực tiếp đến miễn dịch đặc hiệu. Các bệnh tự miễn khiến hệ miễn dịch tấn công tế bào khỏe mạnh, còn rối loạn suy giảm miễn dịch làm giảm khả năng chống nhiễm trùng.
Một số bệnh lý ảnh hưởng trực tiếp đến tế bào lympho T gồm:
Các rối loạn này có thể di truyền hoặc mắc phải nhưng đều ảnh hưởng đáng kể đến khả năng miễn dịch.

Nhìn chung, tế bào lympho T giữ vai trò nền tảng trong hệ thống miễn dịch vì chúng đảm nhiệm nhiệm vụ nhận diện điều phối và tiêu diệt tác nhân gây hại. Những tiến bộ trong sinh học phân tử và y học đã làm sáng tỏ tiềm năng ứng dụng rộng lớn của tế bào này, đặc biệt trong điều trị ung thư và các rối loạn miễn dịch. Việc hiểu rõ cơ chế hoạt động cùng các rối loạn liên quan giúp nâng cao hiệu quả chăm sóc sức khỏe và định hướng điều trị phù hợp trong tương lai.
Dược sĩ Đại họcNguyễn Mỹ Huyền
Dược sĩ Đại học có nhiều năm kinh nghiệm trong việc tư vấn Dược phẩm và hỗ trợ giải đáp thắc mắc về Bệnh học. Hiện đang là giảng viên cho Dược sĩ tại Nhà thuốc Long Châu.